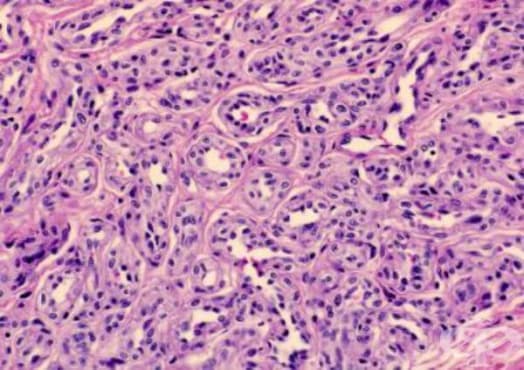

- Какво представляват детските хемангиоми?
- Как изглежда хемангиомът в детска възраст?
- Видове детски хемангиоми
- Каква е причината за поява на хемангиом в детска възраст?
- Кои бебета са с повишен риск от развитие на хемангиоми?
- Ще порастне ли хемангиомът на бебето ми?
- Симптоми и признаци при детски хемангиоми
- Диференциална диагноза на детски хемангиоми
- Диагноза на детски хемангиоми
- Какви проблеми или усложнения могат да причинят инфантилните хемангиоми?
9. Диагноза на детски хемангиоми

В повечето случаи детските хемангиоми обикновено се диагностицират клинично въз основа на анамнезата и констатациите от физикалния преглед. Не са необходими изследвания за по-голямата част от повърхностните лезии. Дълбоките инфантилни хемангиоми или сегментните хемангиоми са рутинно изследвани с образни методи.
Ако има някаква несигурност при разграничаване на хемангиома от други лезии или съдови малформации, извършването на ехография обикновено осигурява окончателен отговор. В някои случаи, ядрено-магнитен резонанс или компютърна томография също могат да бъдат необходими, за да се постави диагноза и да се определи размера на лезията. Възможно е да се направи хистологично изследване за потвърждаване на диагнозата или ако има някакво съмнение относно възможността за злокачествено новообразувание.
Децата с комплексни лезии са най-добре оценени от комисия от експерти, включително педиатър, дерматолог, рентгенолог, офталмолог, съдови и пластични хирурзи.
9.1. Лабораторни изследвания

Няма лабораторни изследвания, които са общоприети за диагностициране на детските хемангиоми.
Въпреки това може да се изследва съдово-ендотелен растежен фактор (VEGF), както и бета-фибробластен растежен фактор и матриксна металопротеиназа (MMP) като маркери на пролиферация и диференциация на хемангиома.
Оцветяването на глюкозен транспортер 1 (GLUT-1) е полезно за оценяване на тъканта, отстранена по време на биопсия или ексцизия. Пролиферативните и инвоюлиращите инфантилни хемангиоми оцветяват положително за GLUT-1, докато други кожни съдови неоплазми, малформации, както и нормалната кожна съдова система не го прави, което прави това изследване много чувствително и специфично за хистологично потвърждение на инфантилни хемангиоми.
9.2. Образни изследвания

Образното изследване на избор при определяне на локализацията и разпространението на кожните и екстракутанните хемангиоми е ядрено-магнитен резонанс с или без използване на контрастно вещество гадолиний. ЯМР също помага за при отдиференцирането на хемангиомите от други съдови лезии.
Ултразвуково изследване е полезно при разграничаването на хемангиомите от други дълбоки дермални или подкожни структури, като кисти или лимфни възли.
Рентгенографията има ограничена употреба, но може да бъде от полза за оценка на хемангиоми, които оказват въздействие върху дихателните пътища.
Прочетете повече информация за изследванията:
9.3. Биопсия

Ако диагнозата все още не е поставена след подробно снетата анамнеза и физикален преглед, биопсия на кожата може да бъде полезна при разграничаване на атипични хемангиоми от други съдови лезии. Тъканните проби могат да бъдат анализирани чрез рутинно хистологично изследване и специфични методи за оцветяване.
Прочетете повече информация за изследването:

Коментари към Детски хемангиоми